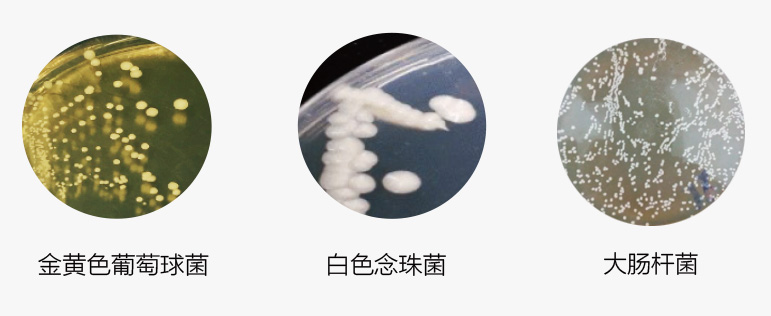
家用呼吸機(jī)不消毒危害

呼吸機(jī)、管路����、面罩在使用時(shí)由于溫度和濕度較高,適合細(xì)菌滋生�����,如大腸桿菌、金黃色葡萄球菌�����、白色念珠菌等�����。如不及時(shí)消毒殺菌����,大量細(xì)菌會(huì)隨著氣流進(jìn)入人體呼吸道,給用戶帶來極大的健康威脅����。特別是慢阻肺患者,可能還會(huì)引起感染�����,誘發(fā)慢阻肺急性加重導(dǎo)致需要入院治療����,給用戶帶來極大的健康威脅和經(jīng)濟(jì)負(fù)擔(dān)。
呼吸機(jī)內(nèi)部和配件樣檢測結(jié)果:
專家建議:家用呼吸機(jī)以及配件應(yīng)最少每7天進(jìn)行一次清潔殺菌�����。

建議使用斯百瑞消毒寶給家用呼吸機(jī)進(jìn)行清潔殺菌!
據(jù)國家權(quán)威機(jī)構(gòu)鑒定:
斯百瑞消毒寶對(duì)大腸桿菌�����、金黃色葡萄球菌����、白色念珠菌
殺菌有效率高達(dá)99.99%����。
溫馨提示:臭氧會(huì)自然分解為氧氣,分解后對(duì)人體無害����。